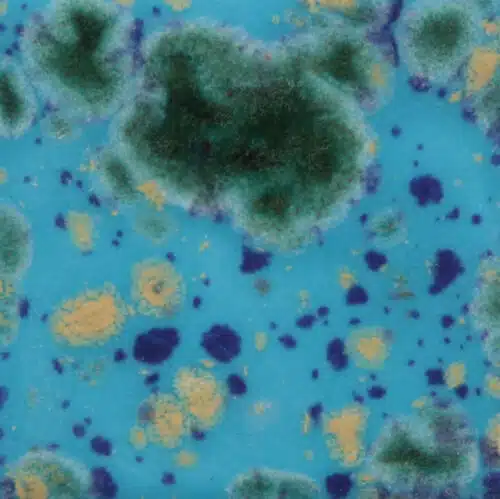
Mayco CG-718 Blue Caprice

-
Pimpelmees 1
3766 AX Soest
T. +31 (0) 35 6012825
E. [email protected]
-
Kristalweg 6
6049 DA Herten
T. +31 (0) 475 520699
E. [email protected]
- Home
- KERAMIEK
- BOETSEREN
- AFVORMEN
- Natuursteen bewerken
- Houtbewerken
- Metaalbewerken
- GIPS/CEMENT/HARS
- VERGULDEN/MOZAIEK
- ATELIERINRICHTING
- SOKKELS/ZUILEN
- BOEKEN/WAARDEBON
- WORKSHOPS
- AANBIEDINGEN
- SALE
- Merken
- Aanbiedingen
- Algemene Voorwaarden
- Veelgestelde vragen